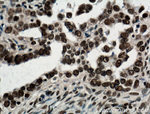
NTF2 Antibody in Immunohistochemistry (Paraffin) (IHC (P))

Search
Proteintech
NTF2 Monoclonal Antibody (4H7F9)
{{$productOrderCtrl.translations['antibody.pdp.commerceCard.promotion.promotions']}}
{{$productOrderCtrl.translations['antibody.pdp.commerceCard.promotion.viewpromo']}}
{{$productOrderCtrl.translations['antibody.pdp.commerceCard.promotion.promocode']}}: {{promo.promoCode}} {{promo.promoTitle}} {{promo.promoDescription}}. {{$productOrderCtrl.translations['antibody.pdp.commerceCard.promotion.learnmore']}}
产品信息
66063-1-IG
种属反应
宿主/亚型
分类
类型
克隆号
抗原
偶联物
形式
浓度
规格
纯化类型
保存液
内含物
保存条件
运输条件
产品详细信息
The MW of this protein is 14 kDa, and this antibody specifically recognizes the 14 kDa protein.
Immunogen sequence: IGSSFIQHY YQLFDNDRTQ LGAIYIDASC LTWEGQQFQG KAAIVEKLSS LPFQKIQHSI TAQDHQPTPD SCIISMVVGQ LKADEDPIMG FHQMFLLKNI NDAWVCTNDM FRLALHNFG (10-127 aa encoded by BC002348)
靶标信息
The protein encoded by this gene is a cytosolic factor that facilitates protein transport into the nucleus. It interacts with the nuclear pore complex glycoprotein p62. This encoded protein acts at a relative late stage of nuclear protein import, subsequent to the initial docking of nuclear import ligand at the nuclear envelope. It is thought to be part of a multicomponent system of cytosolic factors that assemble at the pore complex during nuclear import.
仅用于科研。不用于诊断过程。未经明确授权不得转售。
生物信息学
蛋白别名: NTF-2; Nuclear transport factor 2; NUTF2; Placental protein 15; PP15; unnamed protein product
基因别名: NTF-2; NTF2; NUTF2; PP15
UniProt ID: (Human) P61970
Entrez Gene ID: (Human) 10204